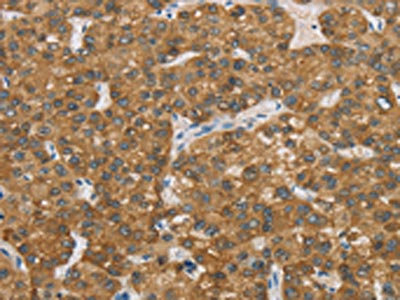

ENTPD5 Antibody
-
中文名稱:ENTPD5兔多克隆抗體
-
貨號:CSB-PA929748
-
規(guī)格:¥1100
-
圖片:
-
The image on the left is immunohistochemistry of paraffin-embedded Human liver cancer tissue using CSB-PA929748(ENTPD5 Antibody) at dilution 1/20, on the right is treated with fusion protein. (Original magnification: ×200)
-
The image on the left is immunohistochemistry of paraffin-embedded Human thyroid cancer tissue using CSB-PA929748(ENTPD5 Antibody) at dilution 1/20, on the right is treated with fusion protein. (Original magnification: ×200)
-
Gel: 8%SDS-PAGE, Lysate: 40 μg, Lane: Mouse liver tissue, Primary antibody: CSB-PA929748(ENTPD5 Antibody) at dilution 1/500, Secondary antibody: Goat anti rabbit IgG at 1/8000 dilution, Exposure time: 5 minutes
-
-
其他:
產(chǎn)品詳情
-
Uniprot No.:
-
基因名:ENTPD5
-
別名:ENTPD5; CD39L4; PCPH; Ectonucleoside triphosphate diphosphohydrolase 5; NTPDase 5; CD39 antigen-like 4; ER-UDPase; Guanosine-diphosphatase ENTPD5; GDPase ENTPD5; Nucleoside diphosphatase; Uridine-diphosphatase ENTPD5; UDPase ENTPD5
-
宿主:Rabbit
-
反應(yīng)種屬:Human,Mouse,Rat
-
免疫原:Fusion protein of Human ENTPD5
-
免疫原種屬:Homo sapiens (Human)
-
標(biāo)記方式:Non-conjugated
-
抗體亞型:IgG
-
純化方式:Antigen affinity purification
-
濃度:It differs from different batches. Please contact us to confirm it.
-
保存緩沖液:-20°C, pH7.4 PBS, 0.05% NaN3, 40% Glycerol
-
產(chǎn)品提供形式:Liquid
-
應(yīng)用范圍:ELISA,WB,IHC
-
推薦稀釋比:
Application Recommended Dilution ELISA 1:1000-1:2000 WB 1:200-1:1000 IHC 1:50-1:200 -
Protocols:
-
儲存條件:Upon receipt, store at -20°C or -80°C. Avoid repeated freeze.
-
貨期:Basically, we can dispatch the products out in 1-3 working days after receiving your orders. Delivery time maybe differs from different purchasing way or location, please kindly consult your local distributors for specific delivery time.
-
用途:For Research Use Only. Not for use in diagnostic or therapeutic procedures.
相關(guān)產(chǎn)品
靶點(diǎn)詳情
-
功能:Uridine diphosphatase (UDPase) that promotes protein N-glycosylation and ATP level regulation. UDP hydrolysis promotes protein N-glycosylation and folding in the endoplasmic reticulum, as well as elevated ATP consumption in the cytosol via an ATP hydrolysis cycle. Together with CMPK1 and AK1, constitutes an ATP hydrolysis cycle that converts ATP to AMP and results in a compensatory increase in aerobic glycolysis. The nucleotide hydrolyzing preference is GDP > IDP > UDP, but not any other nucleoside di-, mono- or triphosphates, nor thiamine pyrophosphate. Plays a key role in the AKT1-PTEN signaling pathway by promoting glycolysis in proliferating cells in response to phosphoinositide 3-kinase (PI3K) signaling.
-
基因功能參考文獻(xiàn):
- ENTPD5 is a mediator of mutant p53 gain of function activity in clonogenic growth, architectural tissue remodeling, migration, invasion, and lung colonization in lung cancer and its mouse models PMID: 27956623
- Results suggest that ENTPD5 affects lung cancer apoptosis via Caspase 3 pathway, and can be potentially used to monitor prognosis or to guide appropriate therapeutic regimens. PMID: 25794010
- The main point of this review is to integrate the findings and proposed theories about the role played by NTPDase5/mt-PCPH in cancer progression, considering that these proteins have been suggested as potential early diagnostic tools and therapy targets. PMID: 25045656
- These results strongly suggest that the mt-PCPH ( ENTPD5)oncoprotein may regulate the cellular energy levels and subsequent chemoresistance by an NTPDase-independent mechanism PMID: 23921441
- Upregulation of ENTPD5 is associated with altered metabolism in gliomablastoma multiforme. PMID: 22992974
- The elevation of ENTPD5 activity therefore protects AKT-active cancer cells from protein-overloading-induced endoplasmic reticulum stress and the resulting growth arrest and apoptosis. PMID: 22169232
- Study reports that ENTPD5, an endoplasmic reticulum (ER) enzyme, is upregulated in cell lines and primary human tumor samples with active AKT. PMID: 21074248
- deregulation and loss of expression in the progression of laryngeal neoplasia [PCPH] PMID: 12489110
- Results positively identify PCPH as a good early molecular marker for testicular neoplasms, and strongly indicate that immunodetection of truncated PCPH polypeptides may be a useful diagnostic tool for testicular germ cell tumors. PMID: 16465363
- PCPH/ENTPD5 expression enhances the invasiveness of human prostate cancer cells by a protein kinase C delta-dependent mechanism PMID: 18006831
- Findings identify PCPH as an important participant in the chemotherapy response of prostate cancer cells and establish a role for PCPH-PKCalpha-Bcl-2 functional interactions in the drug response process. PMID: 19117992
顯示更多
收起更多
-
亞細(xì)胞定位:Endoplasmic reticulum. Secreted.
-
蛋白家族:GDA1/CD39 NTPase family
-
組織特異性:Expressed in adult liver, kidney, prostate, testis and colon. Much weaker expression in other tissues.
-
數(shù)據(jù)庫鏈接:
Most popular with customers
-
-
YWHAB Recombinant Monoclonal Antibody
Applications: ELISA, WB, IHC, IF, FC
Species Reactivity: Human, Mouse, Rat
-
Phospho-YAP1 (S127) Recombinant Monoclonal Antibody
Applications: ELISA, WB, IHC
Species Reactivity: Human
-
-
-
-
-